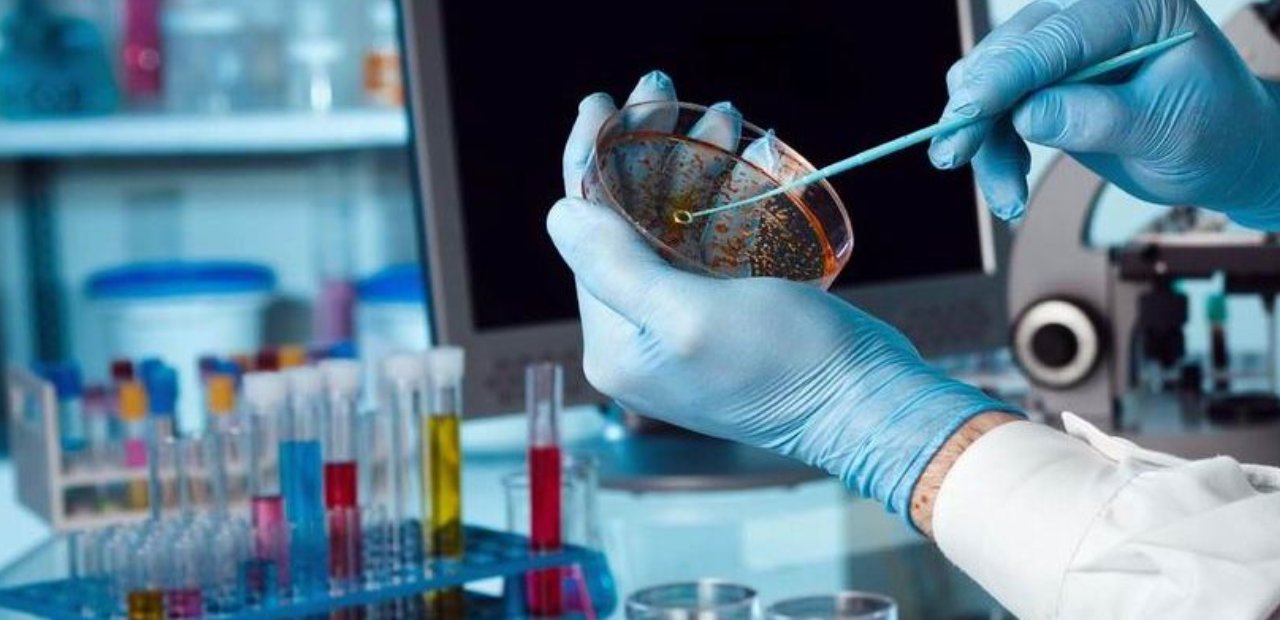

Laboratories & Practical Training Facilities: Bridging Theory and Practice
Medical education thrives on hands-on learning, and Navy Medical College, Chattogram (NMCC) ensures this through a wide range of modern laboratories:

Designed to accommodate multiple groups of students simultaneously, with preserved cadavers, prosected specimens, and advanced models. This hall allows first- and second-year students to develop a clear understanding of human body structure.

Equipped with high-resolution microscopes and digital imaging systems for microscopic study of tissues and cells.

Outfitted with modern instruments for experiments and practical demonstrations on body functions, biochemistry reactions, and molecular biology.
Equipped for slide preparation, staining, microbial culture, and clinical diagnostic training.

This lab is Under Construction

This lab is Under Construction

One of the unique hallmarks of Navy Medical College, Chattogram (NMCC) is the establishment of a Simulation Laboratory from inception — the first of its kind among medical colleges in Bangladesh.
This laboratory ensures that students gain confidence and competence before interacting with real patients, thus bridging the gap between theory and practice.